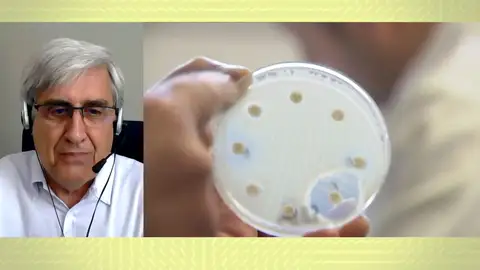
La viruela del mono. La viruela del mono.

Viruela del mono
La vacuna que ya tiene parte de la población española y protege contra la viruela del mono
Juan José Badiola, veterinario e investigador español, explica cuál es el método de transmisión de la viruela del mono que ya ha llegado a nuestro país. Además, advierte que existe una vacuna, con la que ya cuenta buena parte de la población, que protege frente a esta enfermedad.
Publicidad
Apunta Juan José Badiola que el virus de la viruela del mono tiene una transmisión en la que se necesita un contacto estrecho entre la persona infectada y la persona sana. El contagio se produce a través de fluidos y o por contagio de vías respiratorias o saliva.
Especialmente peligroso, apunta Badiola, es el contacto con esas pústulas que tienen un alto grado de infectividad. El primer caso que se registró en esta ola de contagios fue en Reino Unido fue el de un británico que había estado en Nigeria. Actualmente se está produciendo contagio entre personas que no han estado en África. La gran incógnita es si puede haber infección comunitaria. "Ahora habrá que ver todo con los sospechosos que se confirmen. Analizar caso por caso y ver qué relación habrán tenido unos con otros".
Esta enfermedad comenzó a transmitirse entre animales y de ahí pasó al hombre. Inicialmente era una enfermedad de cierta especie de primates y roedores (ratas y ardillas). En África existe desde hace mucho tiempo. La transmisión en humanos es autolimitante: No se propaga de la misma manera que lo hace el Covid, que es una enfermedad expansiva.
Más Noticias
-
La 'pillada' viral a dos amantes en un concierto de Coldplay desata una tormenta: "O están teniendo una aventura o son muy tímidos"
-
Un ladrón entra a robar en casa de una pareja joven y se queda observando de forma inquietante a los inquilinos mientras duermen desnudos
-
Las okupas del 'hotel de los horrores' de San Blas aseguran que los propietarios les engañaron con 15.000€: "Nos pidieron un listado y llegó la citación"
Avanza el profesor Badiola que la vacuna de la viruela sí protege frente a este virus ya que son virus de la misma familia. "La viruela se erradicó, no existe en la faz de la tierra y solo se guarda en algunos laboratorios especializados por si acaso hace falta para algo", apunta.
Publicidad